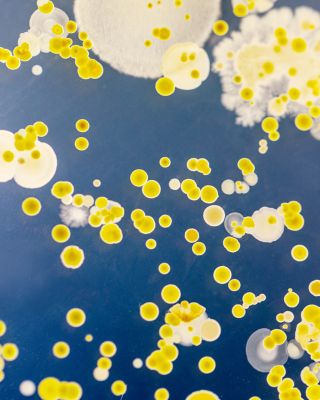
Liposome Advanced Repair Serum 1.7 oz.

Showing All 18 Items
SDD=BOPS=Bath & BodyGift SetsSkin CareYesGift with PurchaseOffers1.STATE3.1 Phillip Lim4AM7 For All Mankind107111SKINA.L.C.Aarkeabercrombie kidsABRAMSAbyssAcqua di ParmaAddison BayAddison RossAdina ReyterAdore MeAdrianna By Adrianna PapellAERINAesopAeydeAFRMAGAGLAGOLDEAgua BenditaAidan MattoxAlberto AmatiAlberto MilaniAlessiAlex MillalexanderwangAlexandre BirmanAlexis BittarAlice and OliviaAll-CladAllen EdmondsALLSAINTSALOHA CollectionALORAlpinaAlternaAltesse StudioAltuzarraAlémaisAme & LuluAmer RugsAmerican LeatherAMIAMOREPACIFICAmurAna LuisaAnabel AramAnabela ChanAnastasia Beverly HillsAncient Greek SandalsAndieAndre AssousAnine BingAnna WeatherleyAnne de SoleneAnnieglassAP BEAUTYApparisAQUAAquazzuraArchitecAREAArea StarsArgento SCArgento VivoARgENTUMArmaniAS by DFAshAssaelAssouline PublishingASTR the LabelAugustinus BaderAxel ArigatoB-low the Beltb.tempt'd by Wacoalba&shBABORBaccaratBadgley MischkaBagatelleBaggalliniBalenciagaBalmainBALMUDABao Bao Issey MiyakeBarbourBardotBAREFOOT DREAMSbareMineralsBarmesBAUBLEBARBaume & MercierBCBGMAXAZRIABeach RiotBeautifectBECCA® by Rebecca VirtueBella DahlBen AmunBenamorBernardaudBernhardtBetsy & AdamBeyond YogaBIA Cordon BleuBicycleBiologique RechercheBirkenstockBits & BowsBlack HaloBlack Suede StudioBLANKNYCBloomingdale'sBloomingdale's Fine CollectionBlue PheasantBluebellaBobbi BrownBOGG BAGBoggi MilanoBoll & Branchbond-eyeBonjourBordallo PinheiroBorgheseBOSSBottega VenetaBraunBric'sBriggs & RileyBright SwimwearBRONX AND BANCOBruno MagliBTB Los AngelesBugabooBulovaBumble and bumbleBurberryBVLGARIBy Adina EdenBY TERRYBÉISC by Bloomingdale's CashmereCADARCala de la CruzCalistaCall it By Your NameCallistaCalvin KleinCamillaCamperCanada GooseCanaliCangshanCanopyCapittanaCapressoCapucine De WulfCara CaraCaracoleCarawayCarreraCartierCastañerCecchi e CecchiCeCeCELINECeremoniaCHANELChantecailleChantelleCharismaCharlotte TilburyChef'nChiara Boni La Petite RobeChilewichChinti & ParkerChloéChristian DiorChristian FischbacherChristian LouboutinChristofleChristophe RobinChristyCiao LuciaCinq à SeptCitizenCitizens of HumanityClare V.ClarinsCliniqueClé de Peau BeautéCOCOACHCoastCocoBellaCole & MasonCole HaanCommandoConiglio Palm BeachCosabellaCosta NovaCotton CitizenCouzonCREEDCristelCrivelliCuisinartCult GaiaCULTI MILANOCUUPCuyanaCXCDame ProductsDavid DonahueDavid WebbDavid YurmanDe Beers Forevermarkde BuyerDe'LonghiDEA Luxury LinensDecortéDEGRENNE ParisDelsey ParisDEMARSONDeMellierDenimistDerek Lam 10 CrosbyDesmond & DempseyDeux par DeuxDinh VanDIORDippin' Daisy'sDIPTYQUEDKNYDL1961Dolce & GabbanaDolce VitaDominique IntimatesDonald PlinerDonna KaranDonna Karan New YorkDonna MorganDR. BARBARA STURMDr. Dennis Gross SkincareDr. Diamond's MetacineDr. Lara DevganDress the PopulationDrowsyDrybarDS & DURGADysonEberjeyEdiktedEF CollectionEichholtzEighth DayEileen FisherEileen WestElanELEMISElephantitoElie TahariEliza JELLE CollectionElliattELODIE THE LABELElrene Home FashionsEmile HenryEmporio ArmaniErno LaszloEscentric MoleculesEssentiel AntwerpEstelle PlusEstée LauderEtho MariaEtonEttikaEVE LOMEX NIHILOEXTENSIBLEF&W StyleFabiana FilippiFahertyFalkeFARM RioFashion FormsFeizyFendiFERRAGAMOFifteen TwentyFitFlopFleur du MalFlora NikroozFloral StreetFlorsheim KidsFOPEFOREFOREOFormeFortessaFPM MilanoFRAASFRAMEFranck MullerFreda SalvadorFrederique ConstantFree PeopleFRENCH CONNECTIONFrescobol CariocaFretteFrida BabyFryeG.H.BASSGANNIGarminGAURI KOHLIGAVAZZENIGeneration LoveGentle Souls by Kenneth ColeGeorg JensenGerard DarelGerson CompanyGiambattista ValliGianvito RossiGigi ClozeauGingerlilyGINIAGinori 1735Giuseppe NicolettiGiuseppe ZanottiGivenchyGlobalGlorioGodingerGodiva®Good AmericanGordon RushGucciGuerlainGuest in ResidenceHairmaxHalcyon DaysHALSTONHamiltonHampton ForgeHanky PankyHanroHartmannharuharu wonderHATCH CollectionhavaianasHEARTS ON FIREHeaven MayhemHeimishHelmut LangHenckelsHerendHEREUHERMÈSHerschel Supply Co.Hervé LégerHestanHigherDOSEHill House HomeHILTLHOBBS LONDONHOKAHOMHoneydewHoneyloveHOORSENBUHSHope & HenryHourglassHudsonHudson Park CollectionHUEHUGOHuppéHyejaHYER GOODSHyggeeIchendorfIgnaeIittalaIl BisonteIluminageIn Bloom by JonquilIngrid & IsabelIPPOLITAIRENE FORTEIsabel MarantIscreamISDINIssey MiyakeITEM m6Jaboneria MarianellaJack BlackJack RogersJACQUEMUSJamie YoungJan LeslieJarsJason Wu CollectionJeffrey CampbellJenni KayneJenny PackhamJimmy ChooJLUXLABELJoe's JeansJohanna OrtizJOHN HARDYJohn RobshawJohn VarvatosJohn Varvatos Star USAJohnny WasJONAS STUDIOJonathan AdlerJoseph JosephJournelleJUAN DE DIOSJuliskaJURAJVNJW AndersonK.JacquesKAF HomeKarastanKARL LAGERFELD PARISKartellKassatexKat Burkikate spade new yorkKatieJnycKay BojesenKay UngerKazuriKendra ScottKenneth ColeKenneth Jay LaneKEVYN AUCOINKiehl's Since 1851KIKI DE MONTPARNASSEKim SeybertKind PatchesKing Baby StudioKitchenAidKiwiCoKnixwearKobi HalperinKosta BodaKuleKURT GEIGER LONDONL'AGENCEL'ObjetL*SpaceL. KleinLa BlancaLa Bonne BrosseLa DoubleJLa MerLa PrairieLafayette 148 New YorkLAGOSLaliqueLANALANCERLancômeLands DownunderLanvinLarroudéLaura MercierLAUREN MOSHILe CreusetLe LaboLe MystèreLe SpecsLele SadoughiLELET NYLenoxLEO LINLeonor GreylLes DeuxLESETLevi'sLevoitLILISLilly PulitzerLILYSILKLine & DotLINK UPLionessLittle GF ChefsLittle GiraffeLittle MeLittle Words ProjectLiv FosterLivablissLive UnlimitedLiverpool Los AngelesLiving ProofLodgeLoeffler RandallLoeweLola + The BoysLolliaLoloiLondontownLongchampLonginesLouis PoulsenLoveShackFancyLSALSPACELucky in LoveLucy ParisLuigi BormioliLUIS MORAISLUMINA NRGLunyaLysséM.M.LaFleurMac DuggalMacKenzie-ChildsMade InMadewellMAGNA-TILESMagnanniMAGNETIC MEMAISON de SABRÉMaison MargielaMajeMajestic FilaturesMalibu SugarMALIN and GOETZMalone SouliersMansur Gavrielmar Y solMarc Fisher LTD.MARC JACOBSMarco BicegoMarcolianiMARGAUXMARIA TASHMarina BMarine LayerMario BadescuMario Luca GiustiMariposaMarkarianMary MeyerMATCHMatoukMaui JimMax HomeMax MaraMAX&Co.Maxim's De ParisMCMMcQueenMDSolarSciencesMediAnswerMeira TMelissa & DougMepraMer St. BarthMessikaMichael AramMichael KorsMichael Kors CollectionMichael WainwrightMICHELEMIDOMieleMikoMilanesi And CoMILLYMIND GAMESMini MelissaMink HomeMiraclesuitMiriam QuevedoMiseno JewelryMisetteMisookMiss CircleMiu MiuMIYABIMizzen+MainModern PicnicMolton BrownMonclerMontaleMontblancMoon & MeadowMoon RiverMoose KnucklesMoroccanoilMoschinoMOTHERMottahedehMount LaiMovadoMunchkinMushieMVMTMZ SKINMZ WALLACEM·A·CNadriNAGHEDINaked WardrobeNambéNARSNashiNasty GalNative UnionNatoriNatori EditNatura BisséNearly NaturalNegativeNespressoNESSI BYRDNEST New YorkNeuhausneuLashNIANIC+ZOENicolettiNikeNinaNina GordonNinjaNippiesNoble PanaceaNOCTURNEnodpodNOHO HOMENordic WareNorma KamaliNude GlassNuFaceNUKNunaNYDJNZT BY NIC+ZOEOak EssentialsOakleyOh La La CheriOLAPLEXOliver PeoplesOlivia BurtonOlivia RiegelOmoroviczaOnOn GossamerOniaOraOradinaORIBEOriental WeaversOrreforsOrvedaOscalitoOscar de la RentaOSEA MalibuOttoman HandsOXOPAIGEPalmaceaPasquale BruniPatBOPatchologyPaul GreenPDPAOLAPeixotoPenhaligon'sPepperperfectwhiteteePeri HomePerricone MDPeter MillarPeter Thomas RothPetite Maison KidsPetite PlumePeugeotPhase EightPHILIP BPhilippe DeshoulieresPhilipsPhilips NorelcoPhillips HousePigeon & PoodlePink ChickenPink LemonadePINKOPIRANESIPistolaPJ SalvagePlatinum inspired by Solange FerrariniPlein SportPointPolo Ralph LaurenPOM POM AT HOMEPomellatoPortierPortmeirionPoupette St. BarthPQ SwimPradaPratesiPre-Owned BreguetPre-Owned BreitlingPre-Owned BvlgariPre-Owned CartierPre-Owned ChopardPre-Owned GoyardPre-Owned HERMÈSPre-Owned Jaeger-LeCoultrePre-Owned OmegaPre-Owned PiagetPre-Owned RolexPre-Owned Van Cleef & ArpelsPRINTWORKSProenza SchoulerProenza Schouler White LabelProfile by GottexProunaPS Paul SmithPUMAPuritoPurple BrandR and CoRabanneRachel ReidRADOrag & boneRailsRainsRalph LaurenRamy BrookRay-BanRaymond WeilRE/DONERebecca MinkoffReed & BartonReformationREISSRene CaovillaRescueMDRetrofeteRhoneRichard BrendonRiedelRipe MaternityRo&ZoRobert TalbottRoberto CoinRoberto DemeglioRodd & GunnRodialROJARonny KoboRose IncRosebud WomanRosendahlRosenthalROTATERothy'sRoxanne AssoulinRoyal AlbertRoyal CopenhagenRoyal Crown DerbyROYCE New YorkRue SophieRya CollectionRylee + CruRéViveSachajuanSafaviehSafiyaaSAINT LAURENTSALONISam EdelmanSamsoniteSanctuarySandroSantoniSantorelliSAU LEESavannah Bee CompanySave The DuckScandia HomeSchlossbergSchott ZwieselSCHUTZSeaSeasalt CornwallSee Kai RunSeiko WatchSelf-PortraitSeltmannSeraxSerge DeNimesSeroVitalSFERRAShahla KarimishaishaishaiSharkShashiShifmanShinolaShiseidoSHONA JOYShunShy CreationSignificant OtherSIMKHAISimone PerelesimplehumanSioniSisley ParisSix FiftySK-IISkarlett BlueSKIMSSkin GymSkinMedicaslipSmegSnapper RockSol & SeleneSolid & StripedSophia WebsterSorelSPANX®SplendidSplits59SpodeSTARSKINSTATEStaubSTAUDStella McCartneySterling ForeverSTEVE MADDENStinaa.JStoney Clover LaneStrathberryStuart WeitzmanStychSugarfinaSulwhasooSUNDAY RILEYSunshine 79Super SmallsSuryaSusan Lanci DesignsSUZANNE KALANSwarovskiSweaty BettySweedSydney EvanT TahariT3Tadashi ShojiTAG HeuerTavoTC Fine IntimatesTed BakerTELETIESTemple St. ClairTeri Jon by Rickie FreemanThe Good JourneyThe Hair EditThe KooplesThe LaundressThe Lulo ProjectThe Men's Store at Bloomingdale'sThe North Face®TheoryTherabodyThink RoylnThistle and SpireThree DotsThuleTiare HawaiiTiffany & Co.Tiny BlessingsTissotTKEESTo Boot New YorkTOCCINTod'sTom FordTommy BahamaTommy JohnTOMSTory BurchTOTEMETouchlandTOV FurnitureTovoloTravelproTRESSÉTrish McEvoy®Troubadour GoodsTrudonTRUE & CO.TumiTwig New YorkU BeautyUbbiUGG®UlikeUncommon GoodsUngaroUNOde50UPPAbabyUrangUwila WarriorV. ChapmanVacationVagabond HouseVagabond ShoemakersValentino GaravaniVanguard FurnitureVera WangVERBVeronica BeardVersaceVersace By RosenthalVersace Jeans CoutureViBi VeneziaVictoria BeckhamVictoria Beckham BeautyVictorinoxVida GlowVIETRIVilebrequinVilleroy & BochVinceVINCE CAMUTOVineyard VinesVirtueVista AlegreVitamixViX Paula HermannyVoluspaVRAIVuoriWacoalWaimariWalters FaithWARDROBE.NYCWaterfordWAYFWedgwoodWee GalleryWeekend Max MaraWhistlesWilliam Yeoward CrystalWinsor & NewtonWolfordWWAKEWYLYSWüsthofxBloomXERJOFFYummieYves DelormeYves Saint LaurentYvonne LéonZadig & VoltaireZadroZEGNAZodiacZoe LevZojirushi AmericaZoë ChiccoZwillingZYDO0|49.9950|100100|5001000|5000MenUnisexWomen